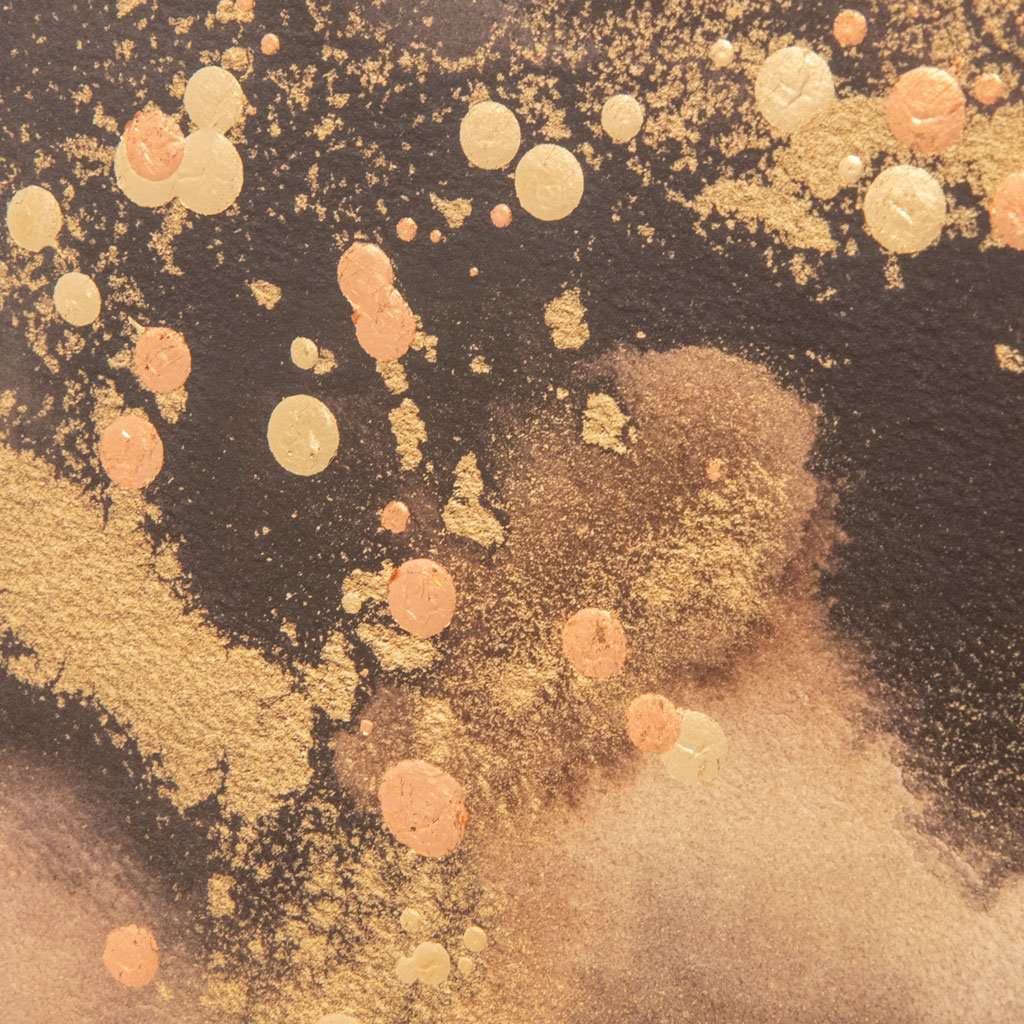

Mountain Moods 1 Oversofa
DISPATCH TIME: 5-7 DAYS
FREE UK DELIVERY
FREE 14 DAY RETURNS
The palette of blended natural earth tones and embellishment with hand applied gold and copper leaf droplets create this subtle artwork.
Signed and individually numbered on a limited print run by the artist Joyce Combs.
Mounted in a sharp white, which is lifted 10 mm away from the artwork to give a 3 dimensional look. The piece is completed and framed in a deep rebate, smoked chrome Italian moulding.
- Signed, Limited Edition of 950 Worldwide
- Matching partner available Mountain Moods 2, and a square pair
- Hand embellished
- Size H 50cm x W 130cm
- Hand made in the UK
Choose options

Mountain Moods 1 Oversofa
Sale price£399.00